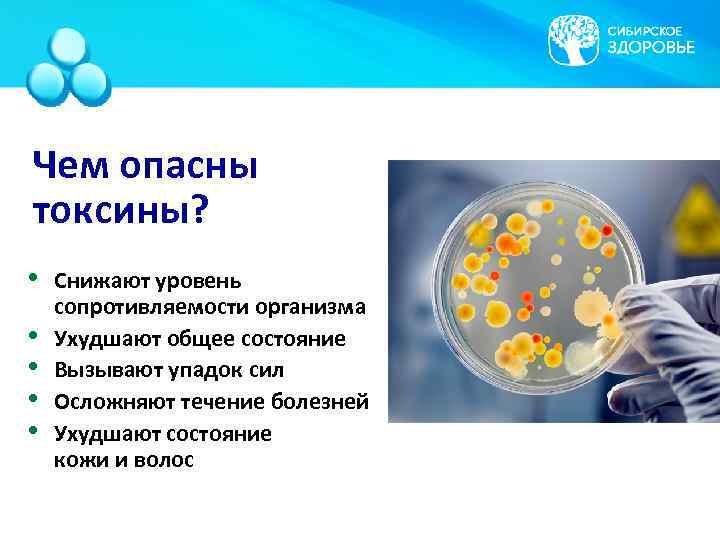

Лимфосан_Россия_11.10.14_RU.pptx
- Количество слайдов: 22

Лимфосаны Натуральные фитосорбенты

Что загрязняет наш организм? • Стерилизованные продукты • Продукты с красителями и ароматизаторами • Жареная пища • Несвежие овощи и фрукты • Алкоголь • Курение • Злоупотребление лекарствами • Загрязненная атмосфера Источники ТОКСИНОВ
Чем опасны токсины? • • • Снижают уровень сопротивляемости организма Ухудшают общее состояние Вызывают упадок сил Осложняют течение болезней Ухудшают состояние кожи и волос

Как бороться с токсинами? Почки Легкие Печень ЖКТ Кожные покровы Нейтрализуют, разрушают, удаляют из организма токсины

Как бороться с токсинами? 1. Исключить из рациона продукты с высоким содержанием токсинов. 2. Включить в рацион свежие, «зеленые» продукты, натуральное зерно. 3. Выпивать не менее 2 л воды в день. 4. Делать физические упражнения. 5. Обогатить рацион КЛЕТЧАТКОЙ.

Очищение и сорбция организма от «Сибирского здоровья»

Лимфосаны Натуральные фитосорбенты

Что такое сорбенты? Сорбенты – тела или вещества, которые поглощают другие вещества своей поверхностью. Фитосорбенты «Лимфосан» – комплекс сорбентов растительного происхождения для безопасного выведения токсинов из организма.

Как работают продукты «Лимфосан» ? Три механизма сорбции механическая сорбция биохимическая сорбция биологическая сорбция

Назначение и свойства: 1. Натуральное очищение организма 2. Детоксикация 3. Стимуляция работы выделительных систем организма 4. Нормализация пищеварения 5. Нормализация кишечной микрофлоры

Как применять «Лимфосан» ? Налейте в высокую кружку 200 мл теплой воды. Размешайте смесь миксером до состояния киселя. В кружку с водой насыпьте 1 чайную ложку «Лимфосана» . Полученную смесь выпейте натощак или примите вместе с пищей.

Преимущество новой ЖЕЛЕЙНОЙ формулы Больше пищевых волокон Усиливает биологические сорбирующие свойства Меньше дозировка Теперь достаточно одной ложки продукта Комфортная для употребления форма Продукт имеет текстуру киселя с приятным вкусом

Лимфосан Базовый Lymphosan Pure Life УНИВЕРСАЛЬНЫЙ ОЧИЩАЮЩИЙ ФИТОСОРБЕНТ Помогает выводить шлаки и токсины из организма СОСТАВ: пектин грейпфрутовый, смола индийской акации (гуар), инулиновый концентрат клубней топинамбура, селективные экстракты алоэ, фенхеля, корня лопуха, листьев оливы, эхинацеи, хвоща, элеутерококка, мартинии, шлемника байкальского, шиповника.

Лимфосан Базовый / Lymphosan Pure Life ПОТРЕБИТЕЛЬСКИЕ СВОЙСТВА КОМПОНЕНТЫ Стимуляция иммунитета Инулиновый концентрат клубней топинамбура Защита от воспалений Экстракты лопуха, алоэ и плодов шиповника Антибактериальное действие Фитонциды из растительных экстрактов Нормализация пищеварения Пищевые волокна (пектин)

Лимфосан-Г Lymphosan Liver Vitality ГЕПАТОПРОТЕКТОРНЫЙ ФИТОСОРБЕНТ Помогает выводить шлаки и токсины, способные повреждать клетки печени СОСТАВ: пектин грейпфрутовый, смола индийской акации (гуар), инулиновый концентрат клубней топинамбура, селективные экстракты алоэ, листьев артишока, ромашки, мяты, чабреца, расторопши, зверобоя.

Лимфосан-Г Lymphosan Liver Vitality ПОТРЕБИТЕЛЬСКИЕ СВОЙСТВА КОМПОНЕНТЫ Нейтрализация опасных химических веществ Природные сорбенты Нормализация кишечной микрофлоры Инулиновый концентрат клубней топинамбура Защита от окисления и повреждения Экстракты алоэ, листьев артишока, ромашки, мяты, чабреца, расторопши Препятствие застою желчи в печени Желчегонные травы

Лимфосан-Ж Lymphosan Female Beauty ЖЕНСКИЙ ФИТОСОРБЕНТ Поддерживает здоровье женщины Является дополнительным источником природных фитоэстрогенов СОСТАВ: пектин грейпфрутовый, смола индийской акации (гуар), инулиновый концентрат клубней топинамбура, селективные экстракты алоэ, кресс-салата, клевера, мяты, виноградных косточек, соевых проростков.

Лимфосан-Ж Lymphosan Female Beauty ПОТРЕБИТЕЛЬСКИЕ СВОЙСТВА КОМПОНЕНТЫ Профилактика возрастных и климактерических нарушений Молодые проростки сои, трава клевера, виноградные косточки Антиоксидантное действие Молодые проростки сои, трава клевера Профилактика остеопороза Инулин, природные фитоэстрогены

Лимфосан К Lymphosan Cardio Balance КАРДИОЛОГИЧЕСКИЙ ФИТОСОРБЕНТ Защита сердечно-сосудистой системы СОСТАВ: цитрусовые пищевые волокна, инулиновый концентрат клубней топинамбура, порошок оболочек семян подорожника (псиллиум), смола индийской акации (гуар), ксантановая камедь, экстракты боярышника и зеленого чая.

Лимфосан К Lymphosan Cardio Balance ПОТРЕБИТЕЛЬСКИЕ СВОЙСТВА КОМПОНЕНТЫ Сорбция холестерина в кишечнике Пищевые волокна (пектин) Защита клеток сердца и сосудов Инулиновый концентрат клубней топинамбура

Полезный коктейль с «ЛИМФОСАНОМ» ФРУКТОВЫЙ Ингредиенты: 100 мл теплой воды, 1 чайная ложка «Лимфосана» , 100– 150 мл любимого сока. КИСЛОМОЛОЧНЫЙ Ингредиенты: 100 мл теплой воды, 1 чайная ложка «Лимфосана» , 100– 150 г кефира, мед, фрукты, орехи, киви. Тщательно перемешать все ингредиенты с помощью миксера, шейкера или вилки.

Спасибо за внимание!
Лимфосан_Россия_11.10.14_RU.pptx